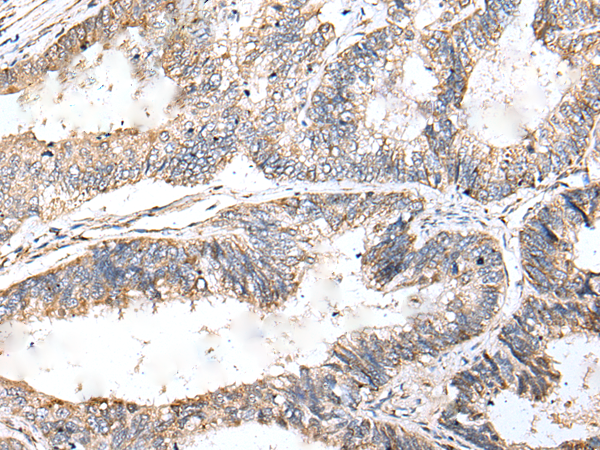
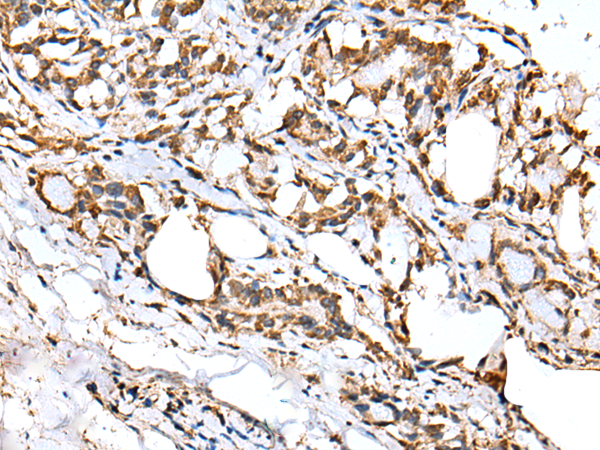
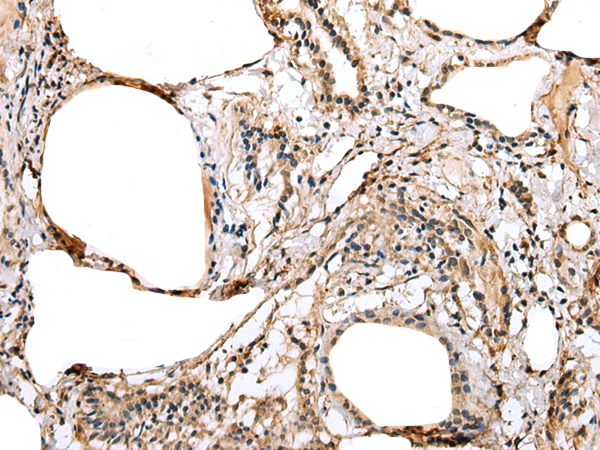
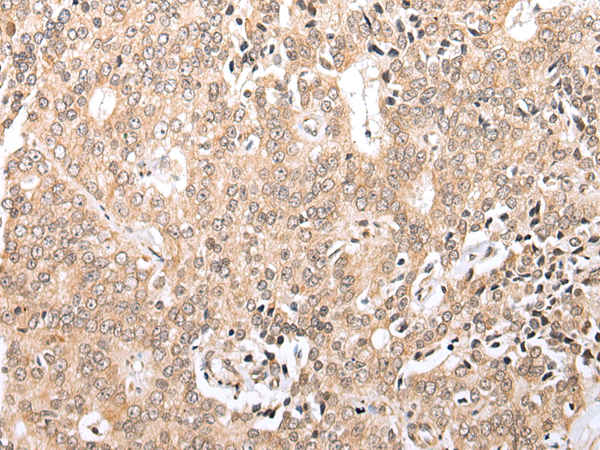

-
分类: 科研抗体货号: P09091别名: HL2; HL-2应用: WB,IHC反应种属: Human
-
分类: 科研抗体货号: P09074别名:应用: IHC反应种属: Human, Mouse, Rat
-
分类: 科研抗体货号: P09080别名: p37应用: IHC反应种属: Human, Mouse, Rat
-
分类: 科研抗体货号: P09090别名: TCTEX1D3应用: WB反应种属: Human, Mouse
-
分类: 科研抗体货号: P09072别名:应用: WB,IHC反应种属: Human
-
分类: 科研抗体货号: P09078别名: KRBO2应用: IHC反应种属: Human
-
分类: 科研抗体货号: P09089别名: H1t; H1.6; H1FT; HIST1H1T; dJ221C16.2应用: WB反应种属: Human, Mouse
-
分类: 科研抗体货号: P09071别名:应用: WB反应种属: Human, Mouse, Rat
-
分类: 科研抗体货号: P09103别名: EPVH; PAR14; PAR17应用: IHC反应种属: Human, Mouse
-
分类: 科研抗体货号: P09088别名: MPN2应用: IHC反应种属: Human

鄂公网安备42018502007531号
鄂公网安备42018502007531号

